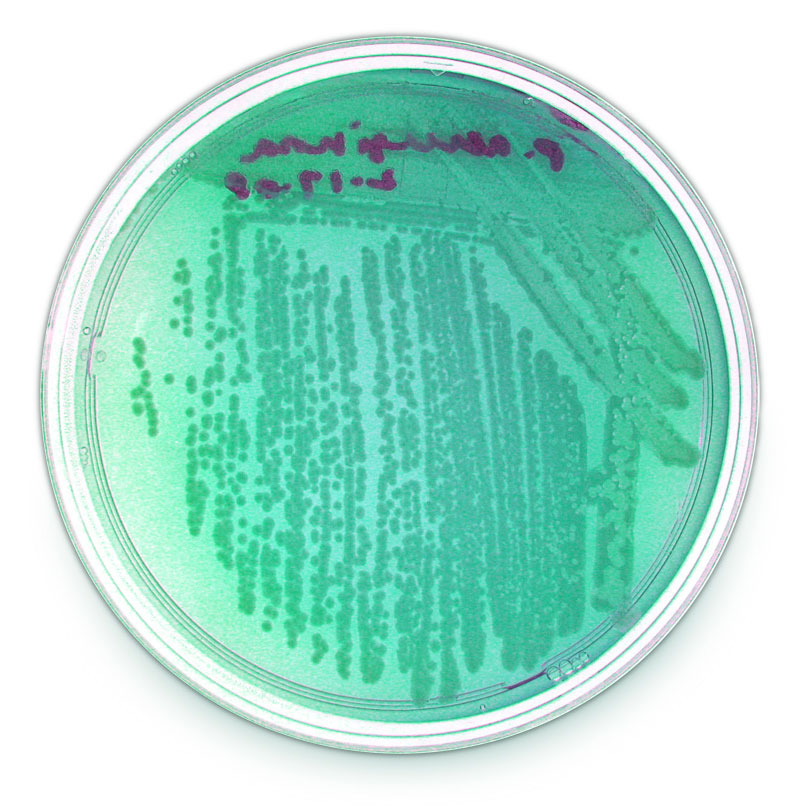
Pseudomonas aeruginosa in Tryptic soy agar - Pseudomonas aeruginosain Tryptic Soy Agar(Image source: Michigan State University)

Tryptic soy agar is a routine laboratory media that supports the growth of a wide variety of non fastidious microorganisms without giving any particular organism a growth advantage.
It is the most commonly used growth medium and is also referred to as soybean casein digest medium (SCDM).
Tryptic soy agar (TSA) is mainly used as an initial growth medium to observe colony morphology, develop a pure culture, and achieve sufficient growth for further biochemical testing and storage. TSA slants are being used to store and ship bacterial cultures.
Composition of Tryptic Soy Agar (TSA)
Final pH 7.3 +/- 0.2 at 25°C
| Ingredients | Amount (gm/L) |
|---|---|
| Pancreatic digest of casein | 15.0gm |
| Peptic digest of soybean meal | 5.0gm |
| Sodium chloride | 5.0gm |
| Agar | 15.0gm |
| Distilled water | 1 liter |
Tryptic soy agar contains digests of casein and soybean meal. The combination of casein and soy peptones renders the medium nutritious by supplying organic nitrogen, particularly amino acids and longer-chained peptides. Sodium chloride is added to maintain the osmotic equilibrium, and agar is the solidifying agent.
Preparation
TSB Medium Preparation
- Weight 3 gm of Tryptic soy broth (TSB) powder and dissolve in 100 ml distilled water.
- Place the bottle on a magnetic stirrer to mix.
- Aliquot 10 ml of the medium to each 13*100 mm glass spiral tube (or other suitable containers as per your need).
- After the aliquot, place all tubes into autoclave at 121°C for 15 minutes.
- Remove the tubes and ensure the tube’s cap is closed tightly.
- Fully cool autoclaved tubes at room temperature before placing stock in a 4°C refrigerator and avoid light. Pre-warm the medium to room temperature before usage.

Uses of Tryptic Soy Agar (TSA)
Tryptic soy agar (TSA) is a general growth medium for isolating and cultivating microorganisms. Tryptic soy agar supports the growth of nonfastidious as well as moderately fastidious microorganisms. This medium is recommended for use in the cultivation, storage, maintenance, and transportation of pure cultures of microorganisms.
Use of TSA in clinical microbiology is limited as it does not support the growth of a variety of fastidious bacteria.
- TSA is not used for isolating pathogens from clinical specimens but may be used for maintaining or subculturing bacterial strains (e.g.,Enterobacteriaceae and Staphylococci).
- After supplementation with blood, TSA may be used as a primary isolation medium in clinical microbiology. Tryptic soy agar with 5% sheep blood is used to test for hemolysis.
- Antimicrobial susceptibility testing of fastidious bacteria, such asS. pneumoniae, S. pyogenes, is done in Mueller Hinton or tryptic soy agar supplemented with 5% sheep blood.
- Tryptic soy agar can be used in determining the X, V, and XV factors requirements of Haemophilusspecies by using strips or discs containing X, V, and XV factors in the inoculated plates.
- Tryptic soy agars containing various salt concentrations are recommended to determine the halotolerant levels of microorganisms.
Uses of Tryptic Soy Broth
- Tryptic soy broth (TSB) is used in blood culture. After venipuncture, blood samples are inoculated into tryptic soy broth containing SPS.
- Tryptic soy broth is used to make 0.5 McFarland suspension and microbroth dilution susceptibility testing of nonfastidious bacteria.
- Tryptic soy broth supplemented with 1% to 2% IsoVitaleX is used to grow F. tularensis.
References and further readings
- Bailey & Scott’s Diagnostic Microbiology, Forbes, 11th edition
- Review of Medical Microbiology and Immunology, Lange Medical Books, 13th edition